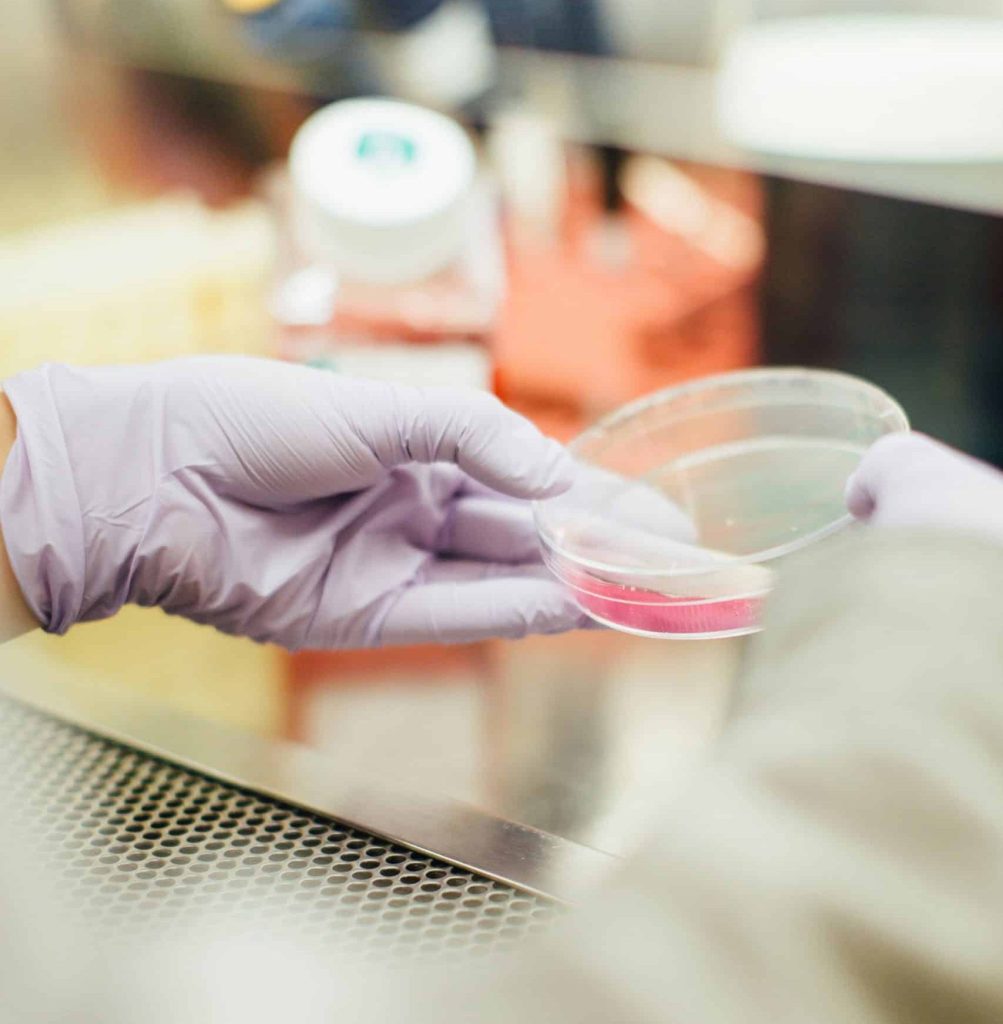

Uma equipa de investigadores descobriu como algumas células do cancro do pâncreas, um dos mais mortais, ganham uma grande vantagem de sobrevivência, o que poderá ter um potencial para tornar os tumores mais vulneráveis aos tratamentos.
O estudo conduzido por investigadores das universidades de Verona e de Glasgow e do Centro Botton-Champalimaud do Cancro Pancreático concluiu que algumas células do cancro do pâncreas “ganham uma grande vantagem de sobrevivência” ao transportarem cópias de genes essenciais do cancro em fragmentos circulares de ADN que existem fora dos cromossomas.
Conhecidos como ADNec, estes anéis genéticos flutuam livremente no núcleo da célula, permitindo que as células tumorais intensifiquem rapidamente a expressão dos genes do cancro, alterem a sua forma e sobrevivam em ambientes que de outra forma lhes seriam hostis.
Segundo a Fundação Champalimaud, o cancro do pâncreas é um dos mais mortais a nível mundial, com uma taxa de sobrevivência de 13% a cinco anos, um mau prognóstico que resulta da deteção tardia, mas também da capacidade para se adaptar e resistir aos tratamentos.
A investigação permitiu agora identificar o “motor oculto desta adaptabilidade”, o ADN extracromossómico.
“O cancro do pâncreas é frequentemente designado como um assassino silencioso porque é difícil de detetar até ser demasiado tarde”, salientou Peter Bailey, coautor do estudo e responsável pela investigação translacional no Centro Botton-Champalimaud do Cancro Pancreático, citado pela Lusa.
De acordo com o investigador, parte dessa letalidade decorre da capacidade de as células tumorais mudarem de forma quando submetidas a stress, com a investigação agora conhecida a demonstrar que o ADNec “constitui uma parte importante dessa história”,
A fundação considerou ainda fundamental que este trabalho permitisse alargar a compreensão da plasticidade genómica, “desafiando a noção” de que o genoma é sempre “fixo”.
“Partimos do princípio de que veríamos sobretudo alterações epigenéticas, pelo que ver este nível de reengenharia genómica foi decididamente uma surpresa”, referiu Peter Bailey.
Tendo em conta a previsão de que os casos de cancro do pâncreas aumentarão nos próximos anos, a compreensão do papel do ADNec poderá servir para futuras estratégias para intercetar ou explorar esta característica genética, “potencialmente tornando os tumores mais vulneráveis aos tratamentos”, realçou ainda Fundação Champalimaud.




